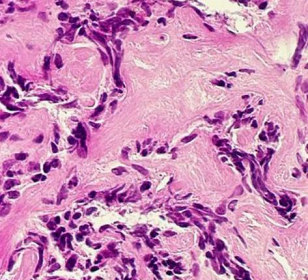

Décrypter deux lymphomes B parmi les plus fréquents pour mieux les traiter grâce au Carnot Calym et le CIML avec le soutien du laboratoire Celgène
<p> Coordonné par Bertrand Nadel, Directeur du Carnot CALYM, directeur de Recherche Inserm et directeur de l’équipe « Instabilité génomique et hémopathies humaines » du Centre d’Immunologie de Marseille-Luminy (CIML, Inserm/AMU/CNRS), le projet ATLAS réunit les équipes scientifiques du CIML (dont l’équipe de P. Milpied), du Carnot CALYM (dont l’équipe de B. Nadel / S. Roulland est membre).</p> <p> ATLAS a pour ambition de fournir une première analyse dynamique à haute résolution de lymphomes folliculaire et diffus à grandes cellules B, dans leur microenvironnement immunitaire. En décryptant, via des techniques d’analyse en cellules uniques, les bases de la physiopathologie de ces cancers, les équipes de recherche vont construire pour chacun d’eux un « Atlas » single-cell RNA-seq sur un grand nombre de patients, afin d’identifier les paramètres biologiques clés associés à la transformation, la croissance tumorale, la rechute et la résistance au traitement.</p> <p> Le projet ATLAS bénéficiera d’échantillons biologiques issus de la collection CeVi de cellules vivantes de lymphomes, mise en place par CALYM, et conditionnés pour l'analyse scRNA-Seq.</p>